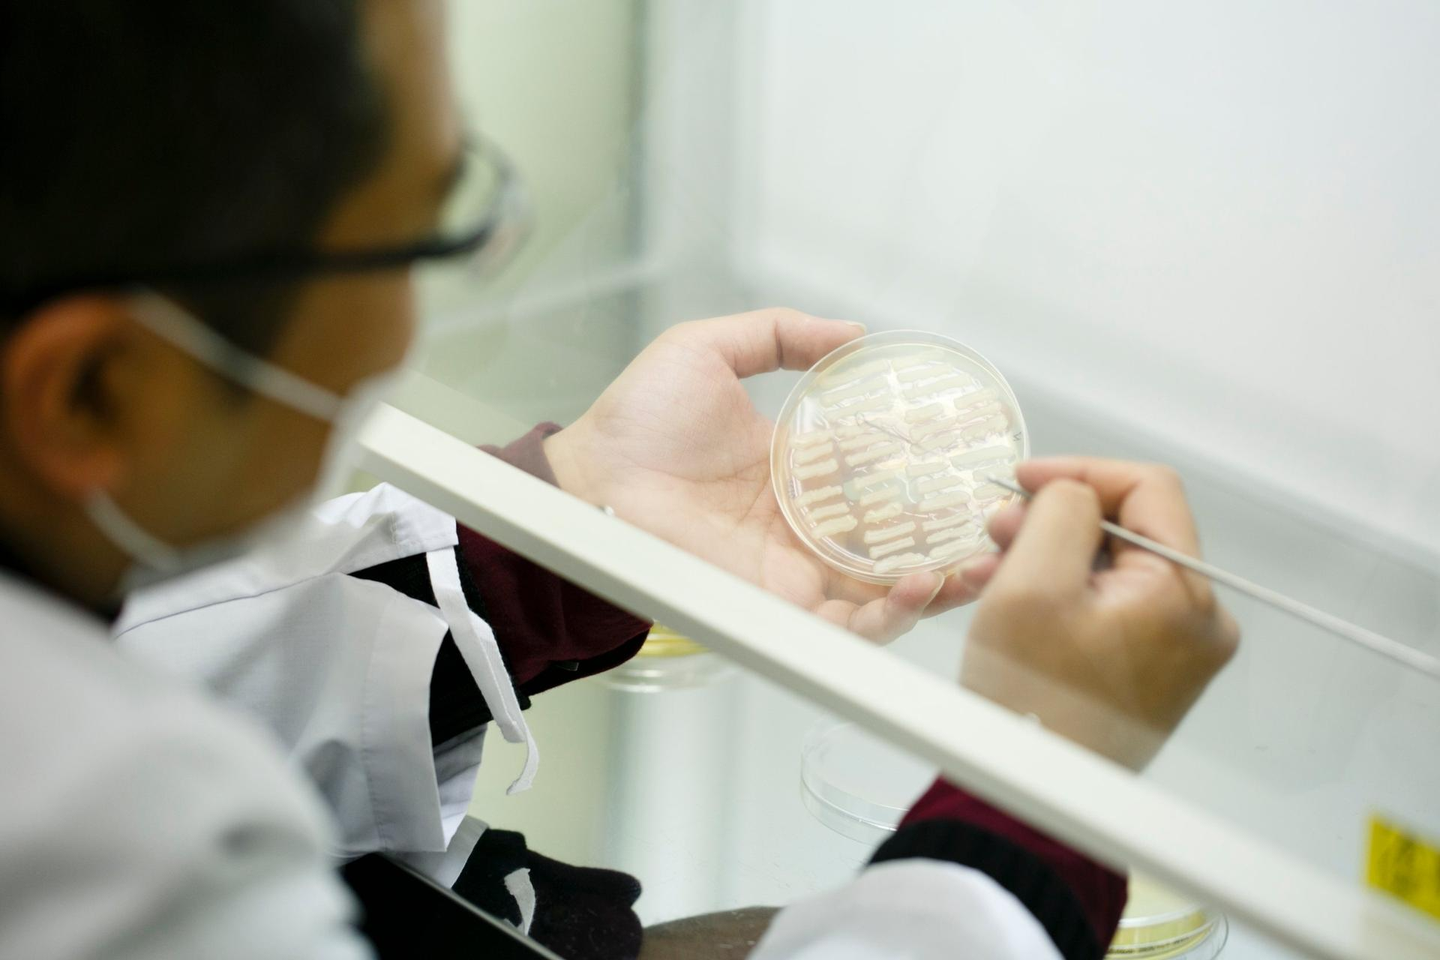

大正時代、田中パンという愛称で親しまれた町の製パン所が、株式会社スタイルブレッドとして焼成冷凍パンの事業を立ち上げて18年。
会社の顔であるスタイルブレッドのパンの品質保証・クオリティを高く保つために欠かせない品質管理部署、QA(クオリティアシュアランス)チームのマネージャー萩原裕也さんにインタビューをしました。
『桐生酵母』に魅了されて
―圧倒的な知識量で社員みんなが頼りにしている萩原さん。
スタイルブレッドに入社するまでの生い立ちを教えてください―
出身は、群馬県。学生時代は海洋学に興味があり、イルカの研究をしたいと思っていました。大学は、沖縄にある琉球大学で遺伝子工学を専攻し、藻類のテロメアについて研究。新卒で健康食品の企業で研究職として5年、沖縄県の第三セクターの技術者として味覚センサーを用いたシークヮーサーやヤギ肉の研究やオリゴ糖を使用した歯周病予防の研究に携わり微生物や食品に纏わる技術者として沖縄に15年ほどいました。
▲スタイルブレッドの天然酵母研究所で独自培養された、自家製酵母種の「桐生酵母」
沖縄に長くいらっしゃったんですね
そうですね、15年ほどいたんですがその後地元に戻り、桐生酵母の存在を知って興味を持ち、スタイルブレッドの本社へ電話をかけました。入社は2015年8月だったので、来年でちょうど丸10年になります。
丸10年!サンクスギビング※ですね、おめでとうございます!
※勤続10年に達した従業員を対象に、5日間の連続した休暇「サンクスホリデー」と感謝金「サンクスボーナス」を支給し、今後の日常生活および勤務に新たな活力をもって取り組むことが出来るようにすることを目的とした制度
長年の経験則をもとに桐生酵母を培養し、安定的保管管理体制のもとで品質が守られています
QAチームのお仕事内容を教えてください
そうですね、お得意先様への品質保証。お客さんの求める品質を会社がつくることです。
常に品質チェックをして、安全・安心な商品をご提供しています。商品品質が保障できないもの、指摘があったものに対しても改善し高品質なパンをご提供できるように努めています。
業務を細かく分けると…
・ISO関連(ハラル認証含む)
~ISO22000について~
食品安全に関する国際規格です(別称 食品安全マネージメントシステム:FSMS)
取得したら終わりではなく、適切に運用することで食品安全リスクの低減、管理体制の強化されていくため、毎年監査が実施されます。
・ISOの運営ができた上での5S(整理・整頓・清掃・清潔・躾)活動
・安全衛生、労災時の対応、製品の状態確認(菌検査、落下テスト・配送テスト)
・お得意先様からのクレーム対応・調査
になります。
個人的な業務としては、新工場の設計、主力のクロワッサンと丸パンの生産効率化、人件費削減(機械への変更)・生産性の向上に現在取り組んでいます。あと社内研修・教育もですね。
社内研修・教育については、入社時、また定期的に講習会を実施しています。個別の勉強会も行い社内の人材育成・スキル向上に努めています。
月例定例、6月度の総会ではバリュー賞「個人の成果よりチームの成果」部門の受賞おめでとうございます!
ファクトリーグループから勉強会を開催したいとの依頼にも応えてかじを取り、又一番大変な夜間帯メンバーとの会も快く承諾してくれて実施。ファクトリーメンバーからは、ファクトリー本部活性化のために引き続き一緒に頑張っていきましょう!というお声がありましたね。
他社と比較してスタイルブレッドのクオリティは正直どうでしょうか
どこと比較するかにもよりますが、同生産規模の食品企業と比較しても品質は高いのではないかと思っています。
実際お得意先様からのクレーム率も下げられてますもんね。
これは社外へ出る前に社内で早期発見・対処できていることが大きく関係しています。ただ目標はゼロなので引き続き尽力します。
最後になりましたが、今後会社でやりたいことはありますか?
お客様が安心してパンを食べられる品質を保持、改善していきたいです。特に異物混入に対しては徹底して追及していきます。
自分自身、分からない原因が分かったときや問題提起に対して改善案を出せることにやりがい・仕事の楽しさを感じています。様々な課題に対して結論・解決策を生み出し、高品質で安全・安心な商品を提供していきたいです。

/assets/images/13069989/original/088226b9-a0a5-490b-9949-0b79f48543a9?1681978303)


/assets/images/13069989/original/088226b9-a0a5-490b-9949-0b79f48543a9?1681978303)
/assets/images/13069989/original/088226b9-a0a5-490b-9949-0b79f48543a9?1681978303)

